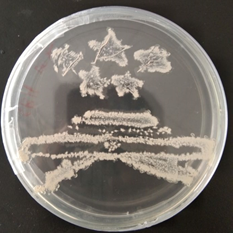

百年岁月,百年辉煌,2021年4月6日,厦门大学将迎来建校100周年华诞。为了迎接百年校庆、展示办学成就、提升科学素养、增强课程质量、推动专业发展。2019年12月26日,“第二届培养基艺术设计大赛”在厦门大学化学化工学院生物化工研究所顺利举行,《微生物学实验》授课教师王远鹏、王海涛老师主持大赛。参与此次比赛的是2017级生物工程本科生。本次大赛分为“平板作画”和“培养基艺术创作”两个赛道,设一、二、三等奖,奖项和获奖队伍名单详见附件1
第二届培养基艺术设计大赛获奖名单.pdf。

(第二届培养基艺术设计大赛签名墙)
参赛学生利用各式各样的微生物作为画笔在多种培养基上作画,该赛事为生物工程专业学生提供了一个学习与展示的平台。比赛过程中,学生们认真投入,积极构思,仔细绘图,大放光彩,一幅幅美轮美奂的培养皿艺术作品浮现眼前;评委老师秉承公平公正的原则对绘图结果进行评判。此次赛事,内容丰富,准备充分,组织严密,充分展示了我校生物工程学生的科学素养。经过四小时的认真创作,比赛顺利结束。

(平板作画一等奖作品献礼祖国母亲70岁生日基于枯草芽孢杆菌和E.coli+RPF在LB培养基上绘画)
本届比赛积极总结以往经验,筹办规模较上一届有较大提升,所利用的培养基、菌种数量远超往届。四位本科生助教准备了色彩鲜艳丰富的各式各样培养基,除了LB等常用培养基外,更以学校“四大精神”代表人物为设计元素,配制了四种培养基:胰蛋白胨大豆琼脂(TSA)培养基营养丰富,利于生长,是微生物的港湾,代表着家国情怀,象征着以陈嘉庚先生为代表的爱国精神;氯化钠蔗糖琼脂(SCSA)培养基以蔗糖为碳源,微生物生长艰难,筚路蓝缕,象征着以萨本栋校长为代表的艰苦办学的自强精神;伊红美蓝琼脂培养基(EMB)培养基颜色鲜红,是甘洒热血的写照,象征着以罗扬才烈士的革命精神;乳酸细菌(MRS)琼脂培养基颜色深沉,给人以稳重严谨的感觉,象征着以王亚南校长、陈景润教授为代表的科学精神。四种元素的有机融合,寓意厦门大学“四大精神”的永续传承和继往开来的坚定决心。“四大精神”是厦门大学最富有典型意义的办学传统和文化特色,是最珍贵的精神财富,始终激励着我们不忘初心、牢记使命、开拓进取、砥砺前行。
(平板作画二等奖作品天安门基于地衣芽孢杆菌在TSA培养基上绘画)

(艺术设计三等奖作品Kill the Rose 基于三孢布拉氏霉的镜检照片)
厦大百年校庆不仅是一次热烈的节庆活动,更是学校百年办学历史的梳理总结和对第一个百年目标的检阅,同时也是再出发的号角和新征程的动员。对于《微生物学实验》课程亦然如此。在接下来实验教学中,两位老师将努力为课程教学献计献策,紧密结合生物工程学科特点,进一步提升教学质量,让学生强化理论认知,熟练掌握实验操作技能,将《微生物学》理论课学习与《微生物学实验》实践课程紧密地结合在一起。在教学内容、教学方法上不断深化改革,创新形式,改变传统教学模式,将创新思维和创新能力培养融入课程教学过程中,加强学生动手能力,练就扎实的微生物实验技能,增强同学们对生物工程以及生命科学的了解和热爱。既可以为同学提供了良好的学习交流平台,又可以成为一个检验《微生物学实验》课程全面学习效果的标准。

(艺术设计一等奖作品Comicbook基于三孢布拉氏霉的镜检照片)
本次“培养基艺术设计大赛”的成功举办,不仅提升了同学们的实验技能,提高了同学们实验设计、实验准备、独立操作、相互协作及分析和解决问题的能力,同时,还加深同学们对生物工程基础知识的理解和掌握,对同学们提高学习相关课程的积极性、增强工程应用能力和拓展视野等诸多方面有着重要的意义,使学生以主动的、实践的、多课程间有机结合的方式进行理论课与实验课程的学习,加强实验课程的设计性、综合性、创新性设计,探索以赛导学、以赛促学的实验教学模式。本课程也将继续积极保持这种创新实验教学模式,不断深化改革,弘扬厦大文化,与母校携手同行,以优异的工作、显著的成绩献礼百年校庆。


来源:https://chem.xmu.edu.cn/info/1273/8252.htm